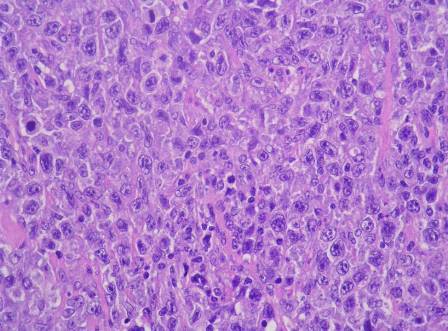

Sinónimos: LCM
Linfoma de la zona del manto
MCL
Prevalencia: 1-9 / 100 000
Herencia: Multigénico / multifactorial
o No aplicable
Edad de inicio o aparición: La edad adulta
Resumen
El linfoma de células del manto es una forma rara del linfoma maligno no Hodgkin (ver este término), que afecta a los linfocitos B en una región de los ganglios linfáticos llamada «zona del manto». Representa el 2-10% de los linfomas.
Su prevalencia se estima en alrededor de 1/25.000.
El linfoma de células del manto afecta a adultos de mediana edad, en particular en torno a los 65 años (extremos: 35-85 años), con una notable predominancia masculina (la ratio hombre/mujer es de 4:1). En el momento del diagnóstico, la mayoría de los pacientes presentan una forma diseminada de la enfermedad.
El linfoma de células del manto frecuentemente se asocia con: adenopatía generalizada (90% de los casos), afectación gastrointestinal (60% de los casos) y afectación medular (55-80% de los casos). Puede aparecer fiebre y una alteración del estado general (fatiga, pérdida de apetito, pérdida de peso). El linfoma de células del manto está causado por una translocación cromosómica t(11;14) (q13;q32), que yuxtapone el gen CCND1 al gen que codifica para la cadena pesada de las inmunoglobulinas, conduciendo a una expresión anormalmente alta de ciclina D1, un regulador del ciclo celular, en el núcleo de las células linfoides.
El diagnóstico se basa en la biopsia de ganglio linfático, que revela la presencia de células tumorales.
El examen inmunohistoquímico fenotípico, así como la evidencia de la expresión anormal de ciclina D1 (o de translocación t(11;14), por FISH o citogenética clásica) son necesarios para confirmar el diagnóstico. La evaluación de la extensión de la enfermedad se realiza mediante técnicas de imagen (ecografía, escáner CT o RM), así como mediante análisis de la médula ósea (biopsia). Los exámenes endoscóspicos deben realizarse para detectar la afectación intestinal.
El diagnóstico diferencial incluye el linfoma folicular (ver este término) y otras formas de linfoma.
El tratamiento del linfoma de células del manto se basa en una quimioterapia intensiva, combinada con anticuerpos monoclonales. En los pacientes más jóvenes, habitualmente se indica un trasplante de células madre autólogas. El torisel (quimioterapia) es un producto que ha recibido la autorización de comercialización en Europa como medicamento huérfano para la enfermedad refractaria o recidivante. Las formas localizadas de la enfermedad pueden beneficiarse de una radioterapia. Algunos pacientes (30%) presentan una respuesta completa a los tratamientos actuales. Las medias de supervivencia globales descritas en la literatura son de 3-5 años.
Revisores expertos
- Dr Vincent RIBRAG
Última actualización: Marzo 2010
Fuente: http://www.orpha.net/consor/cgi-bin/Disease_Search.php?lng=ES&data_id=10693&Disease_Disease_Search_diseaseGroup=LCM&Disease_Disease_Search_diseaseType=Pat&Enfermedade%28s%29/grupo%20de%20enfermedades=Linfoma-de-celulas-del-manto–LCM-&title=Linfoma-de-celulas-del-manto–LCM-&search=Disease_Search_Simple